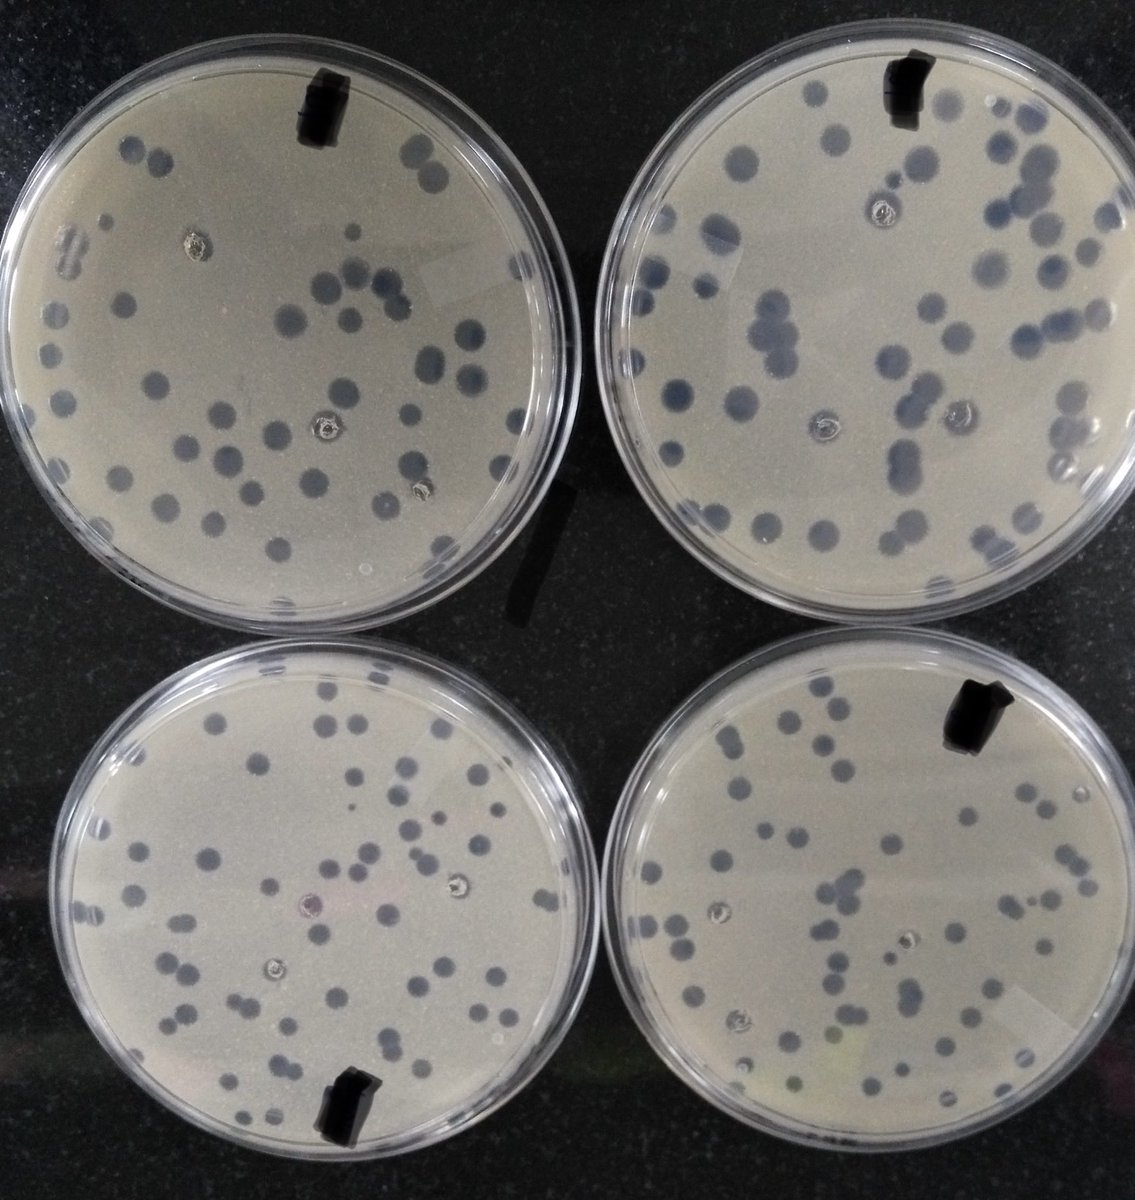
Varun Bavda, PhD tweet media

ทวีตที่ปักหมุด
Mohammed Alarawi | محمد العروي
32.8K posts

Mohammed Alarawi | محمد العروي
@mindmo518
الحمد لله على نعمه التي لا تحصى.
Behind terminal, by the bench. เข้าร่วม Mart 2009
669 กำลังติดตาม839 ผู้ติดตาม

@flyadeal i need to can el flight and the app is not working properly. JB9GSQ
English
Mohammed Alarawi | محمد العروي รีทวีตแล้ว

I belive that the best strategy is to prevent spreading drugs resistant bugs. This is because as long as there is bombardments of antibiotics, bugs will develop resistance to survive the assult.
HananBalkhyحنان بلخي@HananBalkhy
#AMR is a phenomenon where bugs no longer respond to available #antibiotics. @WHO, along with many partners, are working together to implement #AMR Global Action Plan. Awareness is a cornerstone and the humam story is the absolute core. We need every single voice. We need YOU 👇.
English

@mindmo518 Contact support immediately and stop using the computer till the battery is removed. Support will guide you to all the helpful link locations.
English


@Faisal افضل شيء في رأيي. بكسل ممتاز لسبب واحد. نواة اندرويد من جوجل مرتبة افضل ترتيب على عتاد جوجل.
العربية
Mohammed Alarawi | محمد العروي รีทวีตแล้ว
Mohammed Alarawi | محمد العروي รีทวีตแล้ว

A true #happiness for a #phagephan is getting beautiful plaques @phagedirectory @VirusOfMicrobes #phage #bacteriophage #plaques #mycobacterium
English
Mohammed Alarawi | محمد العروي รีทวีตแล้ว

Mohammed Alarawi | محمد العروي รีทวีตแล้ว

#cbrcconf2022. Redefining poster session with paper-free touch screen monitors at @CBRC_KAUST! Definitely impressed!

English
Mohammed Alarawi | محمد العروي รีทวีตแล้ว

Microbiome Data Science gets a great boost at @CBRC_KAUST from SHAHEEN's 200,000 cores! Looking forward to some big data collaborative analysis!


English

@MohRefai @MidoMelebari @Sulaiman_dk @Mohammed1imam @trqziz @MeshaalAlmalki3 @doooooors الشكر لكم جميعا. شرفتونا و آنستمونا. و هذا دورنا كجامعة و كباحثين في نشر العلوم و التعريف بالعلماء. و تعزيز التعاونات البحثية.
العربية

من أجمل وأهم الأمور في المؤتمرات هي الاجتماعات الجانبية والنقاشات العلمية وتكوين العلاقات المختلفة..في #كاوست كان من أهم اهدافي اني اخرج بأكبر قدر ممكن منها.. الحمدلله..تشرفت واجتمعت مع مبدعين عمالقة كنا نعرف بعضنا عن طريق تويتر وصدف تواجدنا في المؤتمر..



Makkah Al Mukarrama, Kingdom of Saudi Arabia 🇸🇦 العربية
Mohammed Alarawi | محمد العروي รีทวีตแล้ว

هنا كاوست
@KAUST_News
حيث أحل ضيف على الجامعة كمتحدث في مؤتمر
Advances in Metagenomics & its applications
شكراً للقائمين على المؤتمر وعلى رأسهم على كرم الضيافة في ليلتي الأولى تحت سماء هذه الجامعة المتميزة محلياً وعالمياً.



العربية
Mohammed Alarawi | محمد العروي รีทวีตแล้ว
Mohammed Alarawi | محمد العروي รีทวีตแล้ว

تشرفت بأن اكون متحدث أمام نخبة من العلماء في أحد أجمل التجمعات العلمية التي حضرتها إن لم يكن هو أجملها. ثلاثة أيام كانت مليئة بالحديث عن آخر ما توصل له العلم في مجالات أبحاث الجينيوم (علم اليمتاجينومك)🧬 كل الشكر لكاوست @KAUST_NewsAR وللمنظمين على تنظيم هذا التجمع العلمي المبهر🙏




العربية








